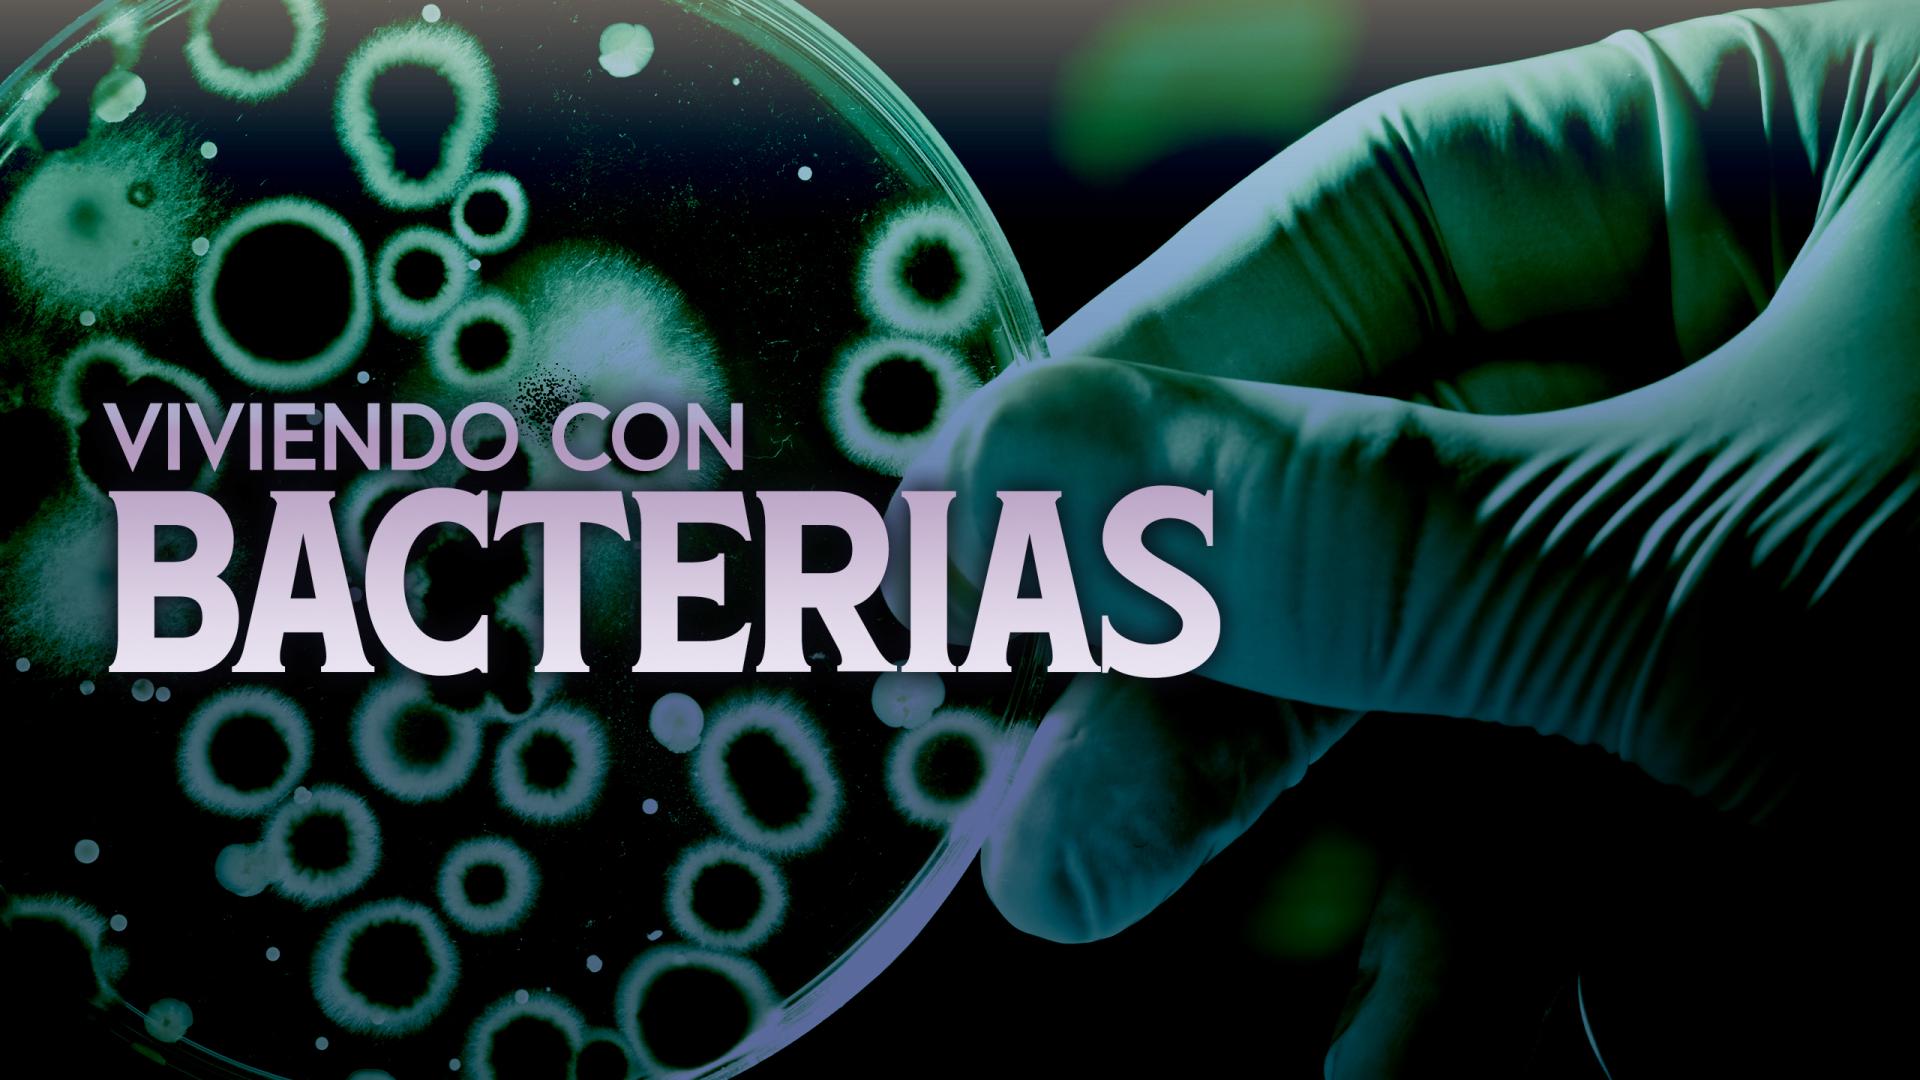

Viviendo con Bacterias
Viviendo con Bacterias
Géneros
Aventura
Documental
Educational
Ciencia
Director(es)
Andrei Timoshchenko
Actor(es)
Andrei Shestakov
Daniil Romashin
Darya Tekucheva
Rosanna Shestakova
Advertisement
